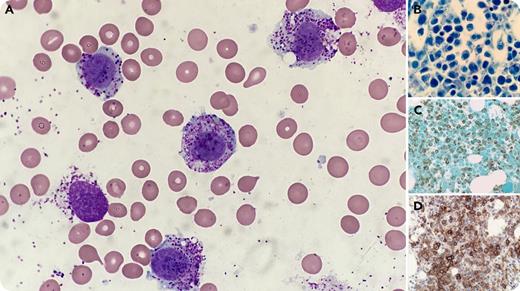
A 35-year-old woman who presented with recurrent episodes of flushing, headache, palpitations, and elevated serum tryptase (81.7 ng/mL) was treated with fexofenadine and imatinib and diagnosed with the aleukemic variant of mast cell leukemia (MCL), defined as a high percentage of mast cells in the bone marrow aspirate (BMA) but no mast cells in the peripheral blood. Cytogenetic studies were normal; however, molecular analysis revealed a KIT D816Y mutation (5.6%), and the patient was started on midostaurin. Evaluation 9 months later revealed disease progression, with BMA (73%) and peripheral blood involvement (18%) by atypical, hypogranular, round-to-oval mast cells (panel A; original magnification ×1000, Wright-Giemsa stain), with expansion of the KIT D816Y clone (13.7%). The bone marrow biopsy showed sheets of mast cells (panel B; original magnification ×1000, Giemsa stain) immunoreactive for mast cell tryptase (panel C; original magnification ×400) and CD25 (panel D; original magnification ×400). / MCL, a rare variant of systemic mastocytosis, typically presents with diffuse marrow involvement and organ damage. Although the majority of advanced mastocytosis cases carry the D816V KIT mutation, alternative mutations or variants, as in this case, have been reported. The aleukemic variant of MCL is more commonly seen, but transformation to overt MCL can occur. The atypical peripheral blood mast cells seen at follow-up were initially erroneously categorized as maturing myeloid cells, a pitfall that could lead to imprecise subclassification of MCL.

A 35-year-old woman who presented with recurrent episodes of flushing, headache, palpitations, and elevated serum tryptase (81.7 ng/mL) was treated with fexofenadine and imatinib and diagnosed with the aleukemic variant of mast cell leukemia (MCL), defined as a high percentage of mast cells in the bone marrow aspirate (BMA) but no mast cells in the peripheral blood. Cytogenetic studies were normal; however, molecular analysis revealed a KIT D816Y mutation (5.6%), and the patient was started on midostaurin. Evaluation 9 months later revealed disease progression, with BMA (73%) and peripheral blood involvement (18%) by atypical, hypogranular, round-to-oval mast cells (panel A; original magnification ×1000, Wright-Giemsa stain), with expansion of the KIT D816Y clone (13.7%). The bone marrow biopsy showed sheets of mast cells (panel B; original magnification ×1000, Giemsa stain) immunoreactive for mast cell tryptase (panel C; original magnification ×400) and CD25 (panel D; original magnification ×400).
MCL, a rare variant of systemic mastocytosis, typically presents with diffuse marrow involvement and organ damage. Although the majority of advanced mastocytosis cases carry the D816V KIT mutation, alternative mutations or variants, as in this case, have been reported. The aleukemic variant of MCL is more commonly seen, but transformation to overt MCL can occur. The atypical peripheral blood mast cells seen at follow-up were initially erroneously categorized as maturing myeloid cells, a pitfall that could lead to imprecise subclassification of MCL.
A 35-year-old woman who presented with recurrent episodes of flushing, headache, palpitations, and elevated serum tryptase (81.7 ng/mL) was treated with fexofenadine and imatinib and diagnosed with the aleukemic variant of mast cell leukemia (MCL), defined as a high percentage of mast cells in the bone marrow aspirate (BMA) but no mast cells in the peripheral blood. Cytogenetic studies were normal; however, molecular analysis revealed a KIT D816Y mutation (5.6%), and the patient was started on midostaurin. Evaluation 9 months later revealed disease progression, with BMA (73%) and peripheral blood involvement (18%) by atypical, hypogranular, round-to-oval mast cells (panel A; original magnification ×1000, Wright-Giemsa stain), with expansion of the KIT D816Y clone (13.7%). The bone marrow biopsy showed sheets of mast cells (panel B; original magnification ×1000, Giemsa stain) immunoreactive for mast cell tryptase (panel C; original magnification ×400) and CD25 (panel D; original magnification ×400).
MCL, a rare variant of systemic mastocytosis, typically presents with diffuse marrow involvement and organ damage. Although the majority of advanced mastocytosis cases carry the D816V KIT mutation, alternative mutations or variants, as in this case, have been reported. The aleukemic variant of MCL is more commonly seen, but transformation to overt MCL can occur. The atypical peripheral blood mast cells seen at follow-up were initially erroneously categorized as maturing myeloid cells, a pitfall that could lead to imprecise subclassification of MCL.
For additional images, visit the ASH Image Bank, a reference and teaching tool that is continually updated with new atlas and case study images. For more information, visit http://imagebank.hematology.org.